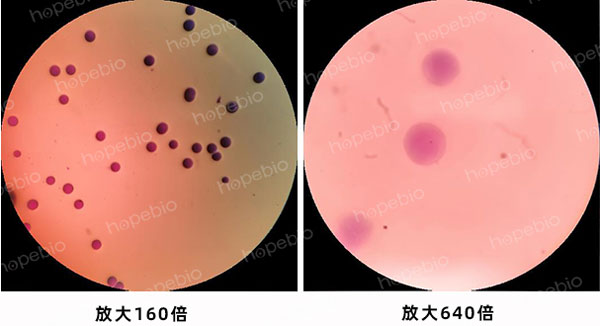

海博微信公众号
海博微信公众号
 海博天猫旗舰店
海博天猫旗舰店


 海博微信公众号
海博微信公众号
 海博天猫旗舰店
海博天猫旗舰店




一、肺炎支原体发病简介
肺炎支原体是人类支原体肺炎的病原体,一旦感染难以完全根治。肺炎支原体感染呼吸道后能借助滑行运动定位于纤毛之间,通过粘附细胞器上的P1黏附素等,黏附于上皮细胞表面,抵抗黏膜纤毛的清除和吞噬细胞的吞噬,并伸出微管插入胞内吸取营养,继而合成过氧化氢等,从而导致细胞的溶解和上皮细胞的氧化应激反应,进而引起炎症。由于肺炎支原体和人体部分组织之间有共同的抗原,在发生肺炎感染之后还可能引起多系统多器官的免疫损害。若是幼儿感染了肺炎支原体,由于自身免疫功能和其他系统器官等的发育不完善,会导致损伤更为严重。不过临床有部分患者症状较轻或无症状。
为肺炎支原体样本的采集、转运保存,我公司专门推出支原体采样管(货号:HBPT077)。
二、支原体采样管的检验原理
酵母浸粉、肉浸粉和血清提供的营养可保证支原体的存活与生长,肺炎支原体生长时可分解葡萄糖产酸导致pH下降,采样管颜色由红变黄,青霉素可抑制多数细菌的生长。
三、支原体采样管的使用方法
1. 采样:取一支支原体采样管,采样前打开包装,该产品配备有采样拭子、采样管、安全袋,在规定的采样部位进行样本采集,可采用最常见的咽拭子采样法,咽拭子的采样手势如图1所示,采样时,先请被检测者张开口,用该消毒过的采样拭子在咽部拭取分泌物,然后放入采样管中,折断拭子尾部手柄,并将尾部手柄放入安全袋中灭菌处理,拧紧采样管后,标记采样管采样人、采样具体时间、采样地点等信息,随后将支原体采样管放入新开启的安全袋中,用于送样检测。

图1 咽拭子的采样手势
2. 培养:运送采样管至实验室,若当天检测可置于4℃冷藏后培养或提取核酸,将该采样管置于36℃培养箱中培养1-3天,若该阳性管由红变黄或为橙黄,且无沉淀或菌膜,报告阳性结果。若采样管出现沉淀或者菌膜,该阳性变化也可能是细菌污染导致的假阳性。当天不检验应-20℃以下低温冻存,避免操作前再次冻融。
四、支原体采样管性能
1. 外观:本品为红色透明液体状。
2. 灵敏度:接种浓度为108CCU/mL的肺炎支原体(ATCC 15531),放置36℃±1℃需氧培养1 d时已有阳性变化,培养至41 h时,结果应为明显的阳性,如图2所示。

图2 接种肺炎支原体培养后的阳性变化
3. 特异性:分别接种1000 CFU的大肠埃希氏菌ATCC 25922、金黄色葡萄球菌ATCC 25923、沙门氏菌ATCC 14028至支原体采样管中,放置36℃±1℃需氧培养1-2天后,结果为阴性,如图3所示。

图3 支原体采样管对常见菌株的抑制作用
五、补充内容-支原体平板培养
虽然支原体采样管中加入了青霉素可抑制大多数杂菌,但仍然有部分杂菌是无法被抑制的,这就可能造成个别假阳性结果,假阳性的表现一般为培养液由红变黄,同时还出现漂浮着的菌膜、培养液底部出现沉淀、培养液变浑浊等现象,如图4所示。

图4 培养液假阳性示例图
(左3支为污染示例,右1支为空白对照)
假阳性现象会干扰结果的判断,有条件允许的情况下除提取核酸外,还可进行固体平板培养,我公司有相应的支原体琼脂培养基平板(货号:HB7025-3),肺炎支原体在固体平板上的生长状态如图5所示。

图5 肺炎支原体在固体平板上的生长状态
肺炎支原体菌落染色镜检形态如图6所示。
图6 肺炎支原体菌落染色镜检
六、支原体采样管使用的注意事项
1. 本品不用于临床诊断;
2. 使用后的培养基应进行消毒处理;
3. 本产品只适用于经过培训的实验人员使用;
4. 本产品使用时,应戴手套和口罩做好防护措施;
5. 产品出现污染,变色,漏液或过期时应禁止使用;
6. 样本标记信息应清晰,样品应及时送检以提高准确性。
相关产品:
上一篇:常用样品、菌株稀释液选择
下一篇:霉菌计数培养基的选择及计数方法



